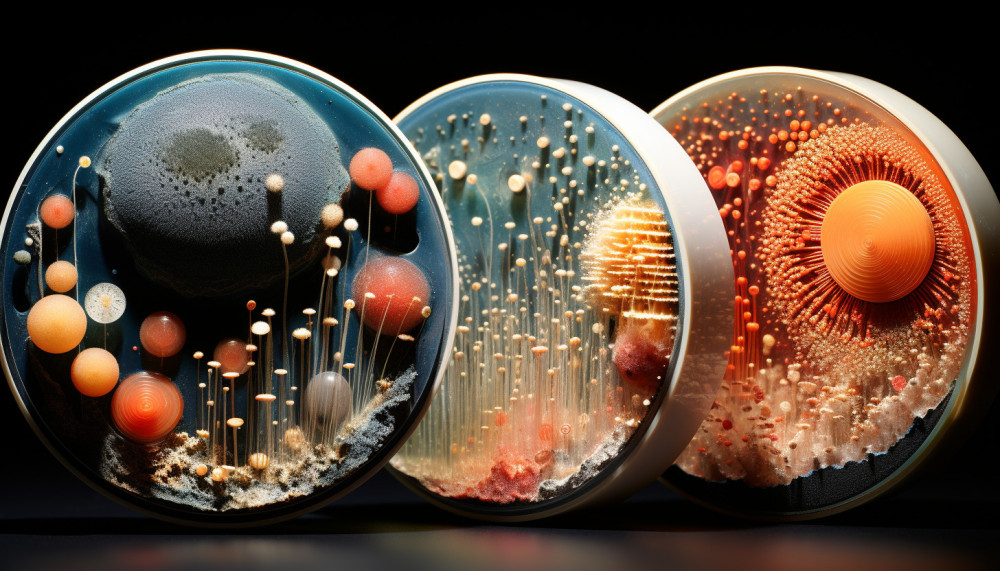
The World in a Grain of Sand: The Beauty of Microscopic Art

Unmasking the Psychological Thrill of Extreme Sports
Extreme sports, a term synonymous with adrenaline, thrill, and a sense of defiance against the conventional norms of safety. It may seem like the enthusiasts of these activities are just adrenaline junkies, seeking the next high. But there's a deeper psychological layer to this adventure-infused...

The Unseen Connection Between Street Art and Urban Renewal
In the realm of urban beautification, street art holds a vital position. The unseen relationship linking street art to urban renewal is a fascinating one, often redefining the aesthetic and social fabric of modern cities. The intricate artwork adorning the city walls, once dismissed as vandalism,...

Decoding the Mysteries of Dark Matter
The universe is an intriguing puzzle, filled with phenomena that challenge our understanding and push us to think beyond our known boundaries. Among these enigmatic concepts is dark matter, an unseen component that makes up approximately 27% of the universe. Despite its invisibility, its...

Unlocking the Secret of Happiness: A Journey into Mindfulness
What is the secret to true happiness? Is it found in material wealth, career success, or the perfect relationship? The answer, it seems, may lie much closer to home. In the realm of our minds, through mindfulness, we can unlock the door to this most sought after emotion. This article will delve...
Science

Understanding The Urgency Of Securing An LEI Code For Business Transactions
In today's fast-paced financial landscape, securing a Legal Entity Identifier (LEI) code is more...

How Free AI Chat Interfaces Revolutionize Online Interactions
In an era where digital communication is paramount, the advent of free AI chat interfaces has...

How Digital Planners Revolutionize Productivity For Tablet Users
In an era where digital tools are transforming the landscape of personal productivity, tablet...

The Impact of Space Travel on Human Evolution
In a universe filled with unknowns, humanity's insatiable quest for knowledge and exploration has...

Decoding the Mysteries of Dark Matter
The universe is an intriguing puzzle, filled with phenomena that challenge our understanding and...
Health and Wellness

The intersection of artificial intelligence and human creativity represents a burgeoning frontier that holds the potential to revolutionize the way we engage with the arts and manage our mental well-being. As AI technology advances, it is becoming increasingly intertwined with the fabric of our...

Immerse yourself in the wonders of Earth's natural environments and discover the profound healing power they possess. This article will guide you on an enlightening journey, offering an exploration of how nature can nurture both mind and body. You'll delve into the therapeutic effects of natural...

What is the secret to true happiness? Is it found in material wealth, career success, or the perfect relationship? The answer, it seems, may lie much closer to home. In the realm of our minds, through mindfulness, we can unlock the door to this most sought after emotion. This article will delve...
Sports & Fitness

In the world of high-stakes motorsport, a driver's psychological resilience can be the deciding factor between victory and defeat. The relentless pressure, lightning-fast decisions, and constant risk demand far more than physical prowess; they require mental agility and emotional regulation....

Climate change, an issue that continues to take center stage in global conversations, is silently unleashing a multitude of threats on every sphere of life, including sports. Global sports, a unifying force that transcends borders, cultures, and languages, is increasingly bearing the brunt of...

Extreme sports, a term synonymous with adrenaline, thrill, and a sense of defiance against the conventional norms of safety. It may seem like the enthusiasts of these activities are just adrenaline junkies, seeking the next high. But there's a deeper psychological layer to this adventure-infused...
Unclassified

What Does A High Number Of Corporate Appointments Suggest About An Executive?
Understanding what a high number of corporate appointments suggests about an executive can reveal...

Enhancing Customer Loyalty Through Expert Support Outsourcing
In the competitive landscape of modern commerce, the loyalty of a customer is a prized asset that...

How To Appoint The Right Registered Agent For Your Business
Selecting a registered agent is a pivotal decision for any business, acting as a bridge between...

How To Choose The Right Online Platform For Your Charity Raffle
Choosing the right online platform for a charity raffle can often be a daunting task. With a...

The World in a Grain of Sand: The Beauty of Microscopic Art
Dive into the mesmerizing world of microscopic art, where the infinitesimal beauty of nature is...
Recent

In today's fast-paced financial landscape, securing a Legal Entity Identifier (LEI) code is more than just a bureaucratic step—it's a necessity for seamless business transactions. Regulatory bodies across the globe now demand LEI registration for companies engaging in cross-border trades and...

Understanding what a high number of corporate appointments suggests about an executive can reveal much about their expertise, reputation, and influence within the business world. This topic is not only relevant for industry insiders but also for anyone interested in the mechanics of corporate...

In the world of high-stakes motorsport, a driver's psychological resilience can be the deciding factor between victory and defeat. The relentless pressure, lightning-fast decisions, and constant risk demand far more than physical prowess; they require mental agility and emotional regulation....

In the competitive landscape of modern commerce, the loyalty of a customer is a prized asset that businesses strive to cultivate and maintain. As organizations increasingly look towards expert support outsourcing to enhance their service quality, understanding the intricacies of this approach...

In an era where digital communication is paramount, the advent of free AI chat interfaces has ushered in a new wave of online interaction possibilities. These innovative tools have begun to reshape the way individuals connect, learn, and conduct business on the web. This exploration delves into...

Selecting a registered agent is a pivotal decision for any business, acting as a bridge between the company and the state. It's not just about meeting legal requirements; it's about ensuring that your business has a reliable point of contact for critical communications. This informative guide...

Choosing the right online platform for a charity raffle can often be a daunting task. With a plethora of options available, it's vital to select a service that not only simplifies the process but also maximizes the potential for fundraising. This post delves into essential considerations that...

In an era where digital tools are transforming the landscape of personal productivity, tablet users are discovering an innovative ally: digital planners. These sophisticated electronic organizers cater to the intricate demands of modern life, allowing users to harness the full potential of their...

The intersection of artificial intelligence and human creativity represents a burgeoning frontier that holds the potential to revolutionize the way we engage with the arts and manage our mental well-being. As AI technology advances, it is becoming increasingly intertwined with the fabric of our...
Dive into the mesmerizing world of microscopic art, where the infinitesimal beauty of nature is magnified into breathtaking visuals. This intriguing art form explores the microscopic realm, revealing a world unseen by the naked eye. Be it the enchanting patterns found in sand grains or the...

Climate change, an issue that continues to take center stage in global conversations, is silently unleashing a multitude of threats on every sphere of life, including sports. Global sports, a unifying force that transcends borders, cultures, and languages, is increasingly bearing the brunt of...

Immerse yourself in the wonders of Earth's natural environments and discover the profound healing power they possess. This article will guide you on an enlightening journey, offering an exploration of how nature can nurture both mind and body. You'll delve into the therapeutic effects of natural...

In a universe filled with unknowns, humanity's insatiable quest for knowledge and exploration has found a new frontier: space travel. We have come a long way from merely observing the cosmos through telescopes to developing technologies that allow us to venture into the vastness of the universe....

In the rapidly evolving digital landscape, classic literature is experiencing a renaissance. The intersection of technology and literature is forging new paths for readers, authors, and educators alike. This resurgence is not just about digitizing pages; it's about using technology to enhance,...

Time, an enigma that constantly eludes the grasp of our understanding, yet remains a crucial element of our existence. This essential thread of reality is ubiquitous, yet we often fail to grasp its true essence. The article attempts to explore time from a philosophical standpoint, delving deeper...

What is the secret to true happiness? Is it found in material wealth, career success, or the perfect relationship? The answer, it seems, may lie much closer to home. In the realm of our minds, through mindfulness, we can unlock the door to this most sought after emotion. This article will delve...

The universe is an intriguing puzzle, filled with phenomena that challenge our understanding and push us to think beyond our known boundaries. Among these enigmatic concepts is dark matter, an unseen component that makes up approximately 27% of the universe. Despite its invisibility, its...

In the realm of urban beautification, street art holds a vital position. The unseen relationship linking street art to urban renewal is a fascinating one, often redefining the aesthetic and social fabric of modern cities. The intricate artwork adorning the city walls, once dismissed as vandalism,...

Extreme sports, a term synonymous with adrenaline, thrill, and a sense of defiance against the conventional norms of safety. It may seem like the enthusiasts of these activities are just adrenaline junkies, seeking the next high. But there's a deeper psychological layer to this adventure-infused...

Living off-grid is an increasingly popular lifestyle choice for those seeking freedom from the constraints of modern society. By disconnecting from the grid, individuals can embrace a self-sustaining way of life that offers numerous benefits, but also comes with its fair share of challenges.
The...

In recent years, virtual reality (VR) has emerged as a powerful tool that is revolutionizing various industries. From gaming to education, VR technology is being utilized in innovative ways to enhance and transform experiences. Mental health professionals have also recognized the immense potential...

For decades, scientists have been tirelessly working on finding a practical solution to meet the world's growing energy demands. One potential answer that has captured the imagination of many is fusion power. By harnessing the same process that powers the sun, fusion power could provide clean,...

The Fascinating Phenomenon of Synesthesia
Synesthesia is a captivating neurological condition that blurs the lines between different senses. It is a rare phenomenon where individuals experience a blending or merging of their senses, resulting in unique sensory perceptions. In simple terms,...

The Rise of the Zero-Waste Movement
With growing concerns about the environmental impact of our daily lives, more and more people are rethinking waste and adopting a zero-waste lifestyle. This movement focuses on reducing the amount of garbage we produce by making conscious choices and finding...